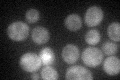
YHL013C
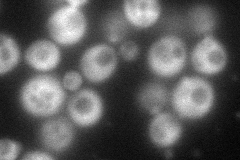
YHL013C
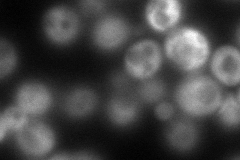
YHL013C
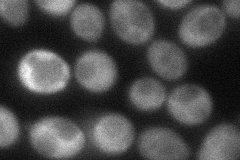
YHL013C
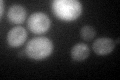
YHL013C
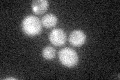
YHL013C

View description
Protein of unknown function that may interact with ribosomes, based on co-purification experiments; member of the ovarian tumor-like (OTU) superfamily of predicted cysteine proteases; shows cytoplasmic localization
Localization:
Intensity:
Fold change:
Significance:
-
C’ GFP library in SD
cytosol30.61 -
N' NOP1pr-GFP in SD
cytosol113.474 -
N' TEF2pr-mCherry in SD
cytosol146.874 -
N' NATIVEpr-GFP in SD

below threshold36.6027 -
N' TEF2pr-VC and Cyto-VN in SD
cytosol57.3413 -
C’ GFP library in SD+DTT
cytosol32.271.05No -
C’ GFP library in SD+H2O2
cytosol32.031.04No -
C’ GFP library in Starvation Media

cytosol32.821.07No -
C’ GFP library on the background of Pup2-DaMP

N/A -
C’ GFP library on the background of CCT mutant

N/A0N/AYes
